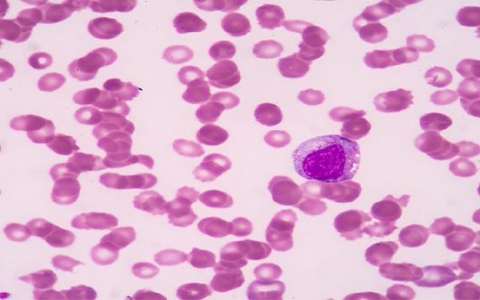
胃窦凹陷会癌变吗？四大症状需警惕！

医疗健康
-
破伤风的主动免疫是什么
破伤风的主动免疫是通过注射疫苗来帮助身体产生抗体,从而预防破伤风梭菌感染的一种方法。破伤风是一种急性传染病,常因外伤导致肌肉痉挛。尤其是当伤口较深且受污染时,感
-
胃窦凹陷会癌变吗?四大症状需警惕!
胃窦凹陷是否具有恶性几率是一个复杂的问题,涉及多种因素。胃窦是胃的一个重要部位,位于胃底和幽门之间。胃窦出现凹陷并不一定意味着恶性病变,可能是由多种原因引起的,
-
吃了蛋黄胃疼怎么办缓解
吃了蛋黄后感到胃疼可能让人感到不适,这通常与摄入过多蛋白质、消化不良、急性胃肠炎或胆囊炎等因素有关。为了缓解这种不适,建议尽快就医,明确病因后在医生指导下进行相
-
肛周炎会使尾椎骨疼痛吗
肛周炎确实可能导致尾椎骨部位出现疼痛的症状。这个问题的背后,其实是因为肛周炎是一种发生在肛门和肛管周围的炎症性疾病,它会引起局部红肿、发热和疼痛等症状。当这种炎
-
大便带血块?警惕这些健康信号,及时就医保健康!
如果您发现大便中有血块,可能会感到非常担心。这个症状可能由多种原因引起,包括痔疮、肛裂和直肠息肉等。为了确保健康,建议尽快就医以明确病因并进行适当的治疗。1、痔
-
肛门周围发黑是怎么回事
肛门周围发黑可能让人感到困惑甚至担忧,但其实,这种现象通常由色素沉着、痔疮或肛裂等常见原因引起。为了确保健康,建议尽早就医,明确病因后进行针对性治疗。色素沉着可
-
吃饭呕吐嘴里有酸的感觉
吃饭后呕吐并伴有嘴里酸酸的感觉,可能是多种因素引起的,比如饮食不当、消化不良、胃炎或胃溃疡等。这种情况可能会让人感到不适,因此及时就医并在医生指导下进行治疗是非
-
大便又粘又臭是什么原因
如果发现大便又粘又臭,可能是饮食习惯、消化不良或者一些肠胃疾病的信号。尽管有时是因为吃了某些食物,但也可能是消化系统在向你发出警告。了解这些原因有助于你更好地调
-
大便过长不断是什么原因
大便过长不断可能是因为饮食不当或消化不良等生理性因素,也可能与肠易激综合征、肠道菌群失调等病理性因素有关。了解这些原因可以帮助我们更好地调整生活方式和饮食习惯,
-
小朋友睡觉晚上抽搐哭闹
小朋友在晚上睡觉时出现抽搐和哭闹的情况,可能让家长们感到不安。这种现象可能由多种原因引起,例如高热惊厥、维生素及微量元素缺乏、癫痫发作或小儿癫痫等。为了孩子的健